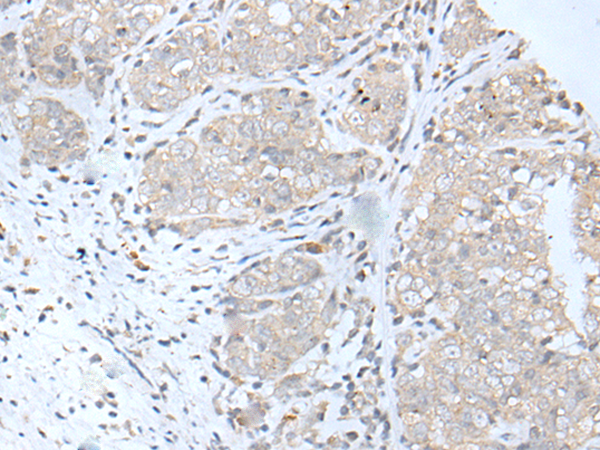

-
分类: 科研抗体货号: P12616别名: CKR4; K5-5; CD194; CMKBR4; ChemR13; CC-CKR-4; HGCN:14099应用: IHC反应种属: Human, Mouse
-
分类: 科研抗体货号: P12593别名: GBD1; ICP3; MDR2; MDR3; PGY3; ABC21; MDR2/3; PFIC-3应用: IHC反应种属: Human
-
分类: 科研抗体货号: P12600别名: GDE应用: WB,IHC反应种属: Human, Mouse
-
分类: 科研抗体货号: P12613别名: NRU; P2P; UNR; P2Y4应用: WB,IHC反应种属: Human, Mouse
-
分类: 科研抗体货号: P12591别名: CNF; NPHN; nephrin应用: IHC反应种属: Human
-
分类: 科研抗体货号: P12598别名: METH2; ADAM-TS8应用: IHC反应种属: Human, Mouse
-
分类: 科研抗体货号: P12612别名: ARHGEF31应用: IHC反应种属: Human, Mouse
-
分类: 科研抗体货号: P12590别名: PRX-4; AOE372; AOE37-2; HEL-S-97n应用: WB,IHC反应种属: Human, Mouse, Rat
-
分类: 科研抗体货号: P12632别名: UMS; XHL; TBX3-ISO应用: WB,IHC反应种属: Human, Mouse, Rat
-
分类: 科研抗体货号: P12610别名: PACAP应用: WB,IHC反应种属: Human, Mouse, Rat

鄂公网安备42018502007531号
鄂公网安备42018502007531号

